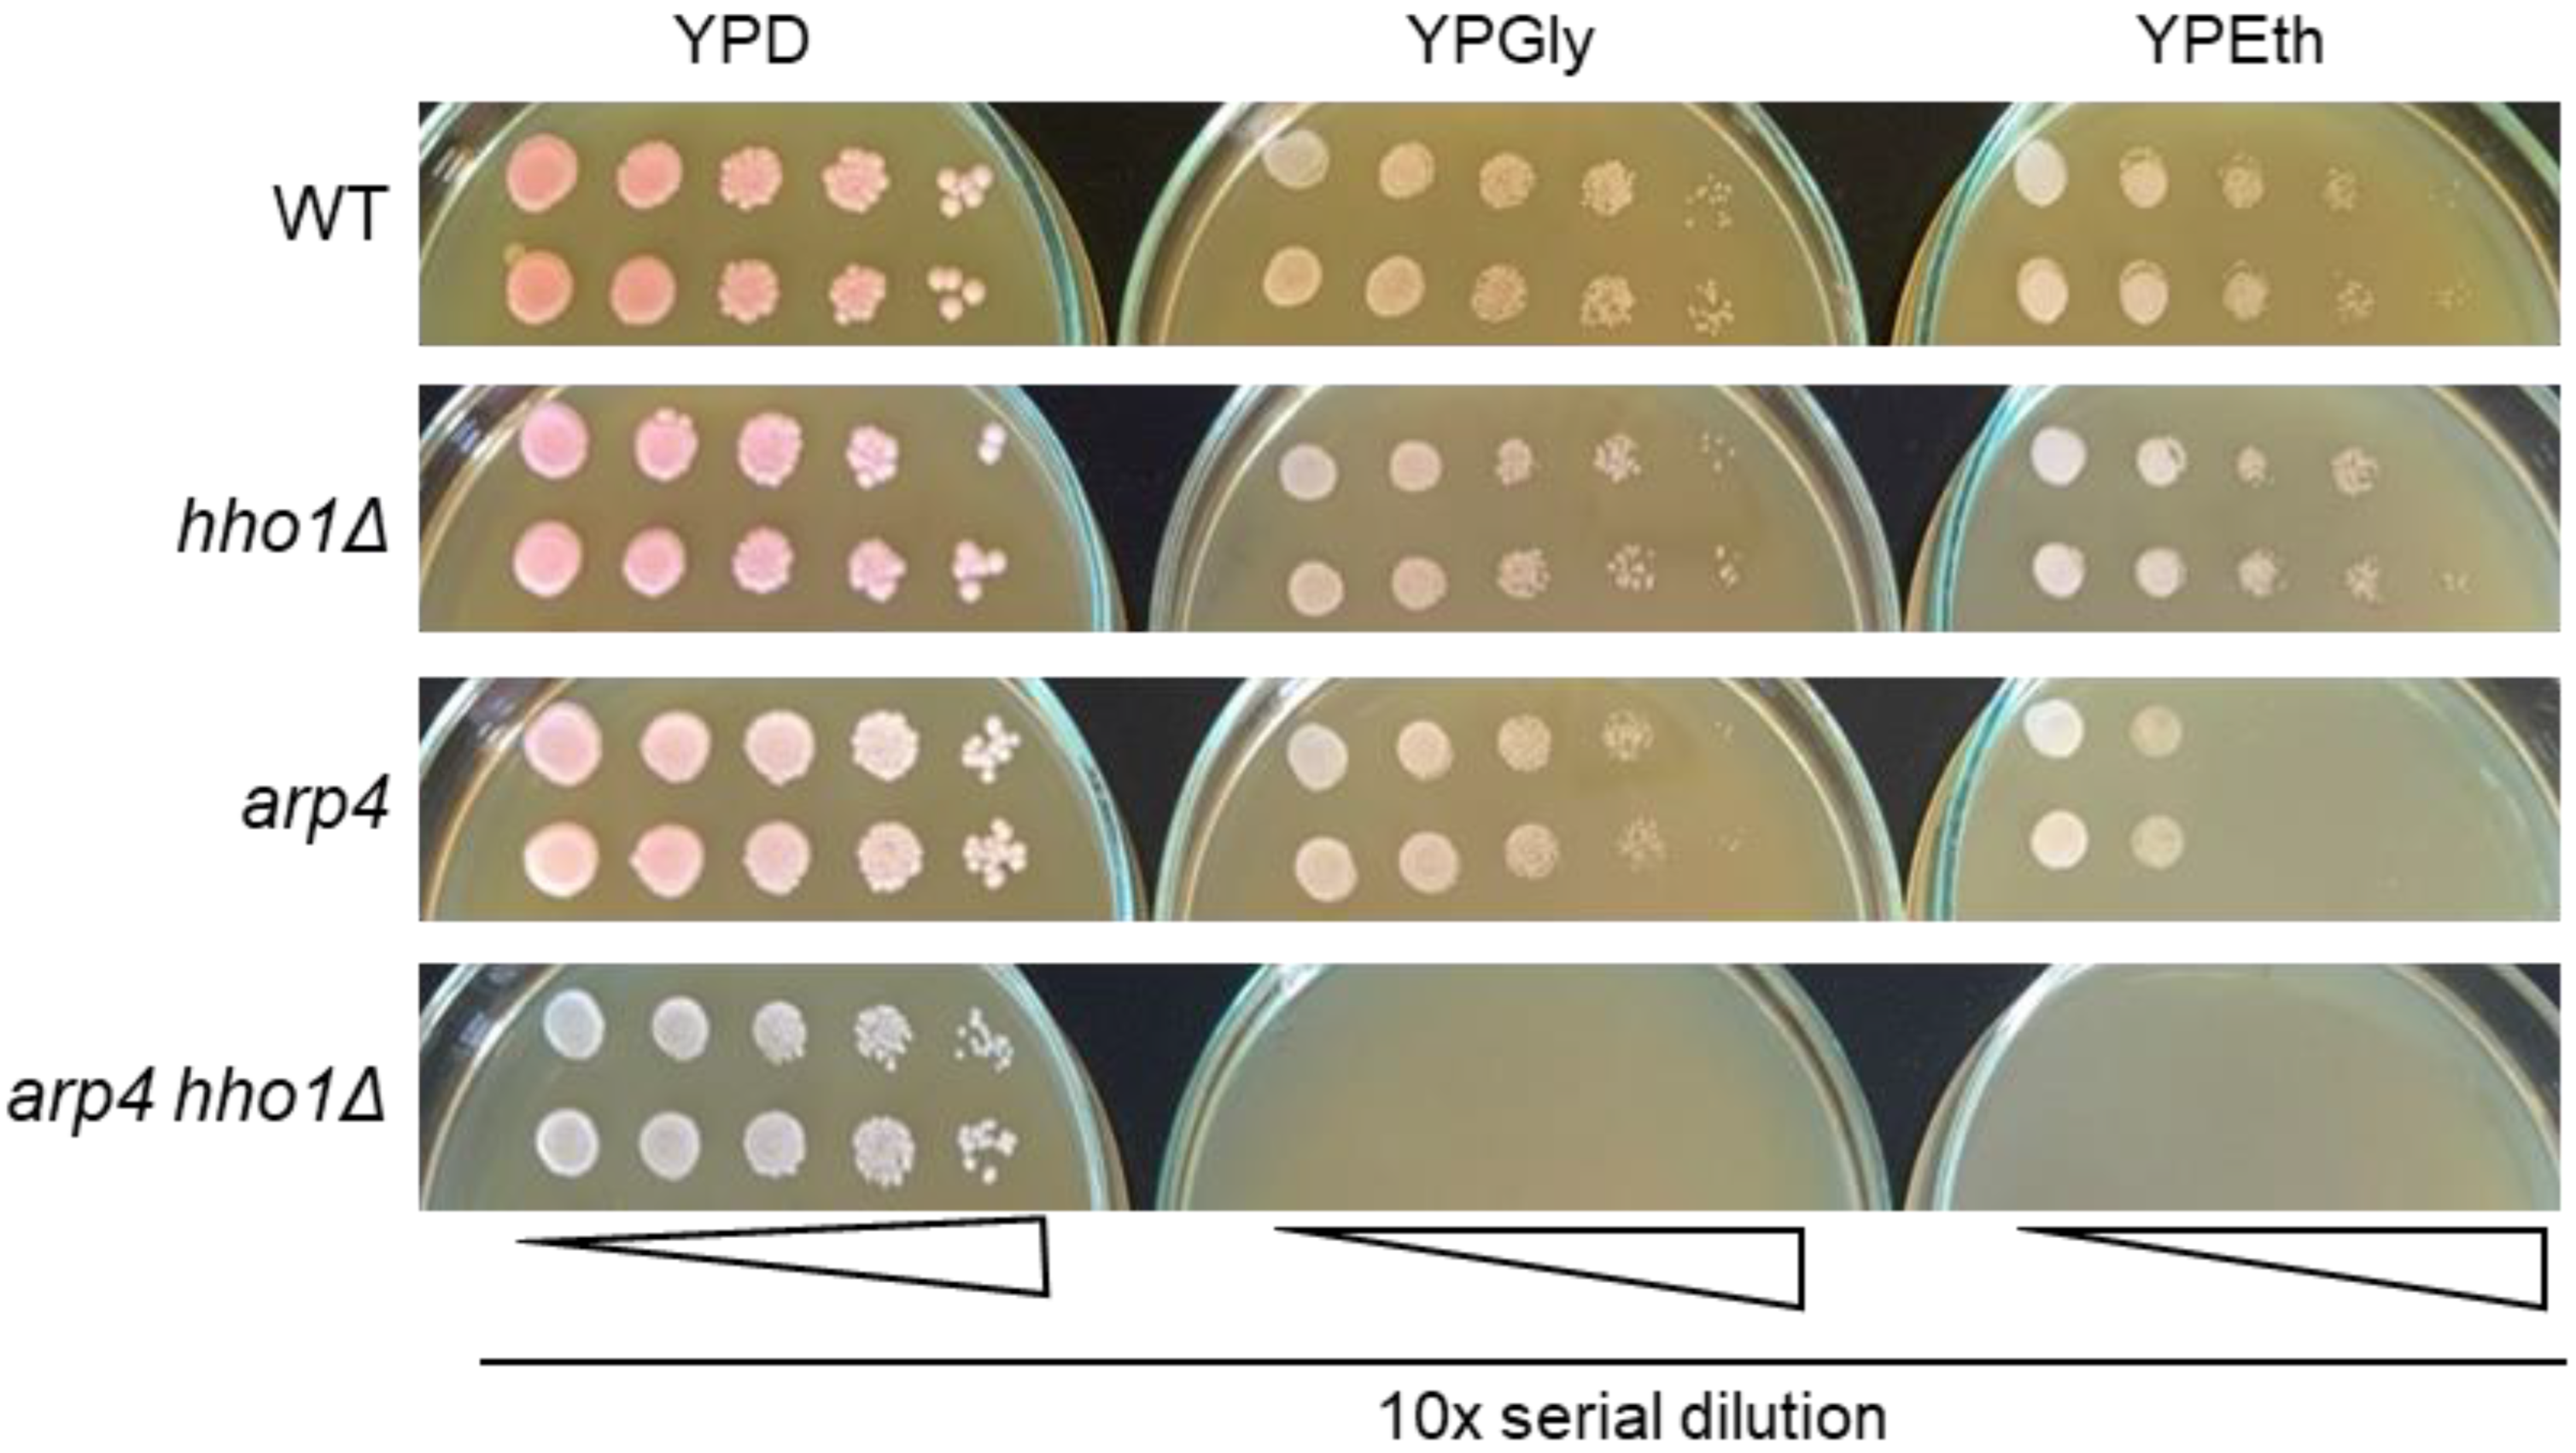

Yeast Chromatin Mutants Reveal Altered mtDNA Copy Number and Impaired Mitochondrial Membrane Potential
Abstract
1. Introduction
2. Materials and Methods
2.1. Yeast Strains and Cultivation Conditions
2.2. Replica Plating and Spot Tests
2.3. UVA/B Irradiation
2.4. Total DNA and RNA Preparation and Primers Used in PCR Analyses
2.5. Conventional PCR and Real-Time Quantitative PCR (qPCR) Analyses
2.6. Absolute Quantification of mtDNA Copy Number and ATG18 and CDC28 Gene Expression by Droplet Digital PCR (ddPCR)
2.7. FACS Analysis for Rhodamine 123 Staining
2.8. Statistical Analyses
3. Results and Discussion
3.1. The Double Mutant arp4 hho1Δ Exhibits Strong “Petite” Phenotype
3.2. mtDNA Integrity
3.3. Mitochondrial DNA Quantification in the Course of Yeast Lifespan
3.3.1. Relative Quantification of mtDNA by qPCR
3.3.2. Absolute Quantification of mtDNA Copy Number
3.4. Rhodamine 123 Staining for Analysis of Mitochondrial Membrane Potential by Flow Cytometry
3.4.1. Dynamics of the Mitochondrial Membrane Potential in Non-UV Irradiated Yeast Cells during CLS
3.4.2. Dynamics of Mitochondrial Potential in UVA/B Irradiated Yeast Cells during CLS
3.5. Selfie-dPCR for Absolute Quantification of ATG18 and CDC28 Transcripts
4. Conclusions
Supplementary Materials
Author Contributions
Funding
Institutional Review Board Statement
Informed Consent Statement
Data Availability Statement
Acknowledgments
Conflicts of Interest
References
- Baile, M.G.; Claypool, S.M. The power of yeast to model diseases of the powerhouse of the cell. Front. Biosci. 2013, 18, 241–278. [Google Scholar] [CrossRef]
- Rutter, J.; Hughes, A.L. Power2: The power of yeast genetics applied to the powerhouse of the cell. Trends Endocrinol. Metab. 2015, 26, 59–68. [Google Scholar] [CrossRef] [PubMed]
- Gilea, A.I.; Ceccatelli Berti, C.; Magistrati, M.; di Punzio, G.; Goffrini, P.; Baruffini, E.; Dallabona, C. Saccharomyces cerevisiae as a Tool for Studying Mutations in Nuclear Genes Involved in Diseases Caused by Mitochondrial DNA Instability. Genes 2021, 12, 1866. [Google Scholar] [CrossRef] [PubMed]
- Ephrussi, B.; Slonimski, P.P. Subcellular units involved in the synthesis of respiratory enzymes in yeast. Nature 1955, 176, 1207–1208. [Google Scholar] [CrossRef]
- Chen, X.J.; Clark-Walker, G.D. The Petite Mutation in Yeasts: 50 Years On. In International Review of Cytology; Jeon, K.W., Ed.; Academic Press: Cambridge, MA, USA, 1999; Volume 194, pp. 197–238. [Google Scholar]
- Chan, D.C. Fusion and fission: Interlinked processes critical for mitochondrial health. Annu. Rev. Genet. 2012, 46, 265–287. [Google Scholar] [CrossRef]
- Lasserre, J.P.; Dautant, A.; Aiyar, R.S.; Kucharczyk, R.; Glatigny, A.; Tribouillard-Tanvier, D.; Rytka, J.; Blondel, M.; Skoczen, N.; Reynier, P.; et al. Yeast as a system for modeling mitochondrial disease mechanisms and discovering therapies. Dis. Model. Mech. 2015, 8, 509–526. [Google Scholar] [CrossRef]
- Schwimmer, C.; Rak, M.; Lefebvre-Legendre, L.; Duvezin-Caubet, S.; Plane, G.; di Rago, J.P. Yeast models of human mitochondrial diseases: From molecular mechanisms to drug screening. Biotechnol. J. 2006, 1, 270–281. [Google Scholar] [CrossRef]
- Baccolo, G.; Stamerra, G.; Coppola, D.P.; Orlandi, I.; Vai, M. Chapter One-Mitochondrial Metabolism and Aging in Yeast. In International Review of Cell and Molecular Biology; López-Otín, C., Galluzzi, L., Eds.; Academic Press: Cambridge, MA, USA, 2018; Volume 340, pp. 1–33. [Google Scholar]
- Fehrmann, S.; Paoletti, C.; Goulev, Y.; Ungureanu, A.; Aguilaniu, H.; Charvin, G. Aging Yeast Cells Undergo a Sharp Entry into Senescence Unrelated to the Loss of Mitochondrial Membrane Potential. Cell Rep. 2013, 5, 1589–1599. [Google Scholar] [CrossRef]
- Volejníková, A.; Hlousková, J.; Sigler, K.; Pichová, A. Vital mitochondrial functions show profound changes during yeast culture ageing. FEMS Yeast Res. 2013, 13, 7–15. [Google Scholar] [CrossRef]
- Scheckhuber, C.Q.; Erjavec, N.; Tinazli, A.; Hamann, A.; Nystrom, T.; Osiewacz, H.D. Reducing mitochondrial fission results in increased life span and fitness of two fungal ageing models. Nat. Cell Biol. 2007, 9, 99–105. [Google Scholar] [CrossRef]
- McFaline-Figueroa, J.R.; Vevea, J.; Swayne, T.C.; Zhou, C.; Liu, C.; Leung, G.; Boldogh, I.R.; Pon, L.A. Mitochondrial quality control during inheritance is associated with lifespan and mother-daughter age asymmetry in budding yeast. Aging Cell 2011, 10, 885–895. [Google Scholar] [CrossRef]
- Pernice, W.M.; Swayne, T.C.; Boldogh, I.R.; Pon, L.A. Mitochondrial Tethers and Their Impact on Lifespan in Budding Yeast. Front. Cell Dev. Biol. 2018, 5, 120. [Google Scholar] [CrossRef]
- Aerts, A.M.; Zabrocki, P.; Govaert, G.; Mathys, J.; Carmona-Gutierrez, D.; Madeo, F.; Winderickx, J.; Cammue, B.P.A.; Thevissen, K. Mitochondrial dysfunction leads to reduced chronological lifespan and increased apoptosis in yeast. FEBS Lett. 2009, 583, 113–117. [Google Scholar] [CrossRef]
- Lai, C.Y.; Jaruga, E.; Borghouts, C.; Jazwinski, S.M. A mutation in the ATP2 gene abrogates the age asymmetry between mother and daughter cells of the yeast Saccharomyces cerevisiae. Genetics 2002, 162, 73–87. [Google Scholar] [CrossRef]
- Veatch, J.R.; McMurray, M.A.; Nelson, Z.W.; Gottschling, D.E. Mitochondrial dysfunction leads to nuclear genome instability via an iron-sulfur cluster defect. Cell 2009, 137, 1247–1258. [Google Scholar] [CrossRef]
- Jazwinski, S.M. The retrograde response: A conserved compensatory reaction to damage from within and from without. Prog. Mol. Biol. Transl. Sci. 2014, 127, 133–154. [Google Scholar] [CrossRef]
- Liu, Z.; Butow, R.A. Mitochondrial retrograde signaling. Annu. Rev. Genet. 2006, 40, 159–185. [Google Scholar] [CrossRef]
- Miceli, M.V.; Jiang, J.C.; Tiwari, A.; Rodriguez-Quinones, J.F.; Jazwinski, S.M. Loss of mitochondrial membrane potential triggers the retrograde response extending yeast replicative lifespan. Front Genet. 2011, 2, 102. [Google Scholar] [CrossRef]
- Woo, D.K.; Poyton, R.O. The absence of a mitochondrial genome in rho0 yeast cells extends lifespan independently of retrograde regulation. Exp. Gerontol. 2009, 44, 390–397. [Google Scholar] [CrossRef]
- Chen, X.J.; Butow, R.A. The organization and inheritance of the mitochondrial genome. Nat. Rev. Genet. 2005, 6, 815–825. [Google Scholar] [CrossRef]
- Rühle, T.; Leister, D. Assembly of F1F0-ATP synthases. Biochim. Biophys. Acta BBA Bioenerg. 2015, 1847, 849–860. [Google Scholar] [CrossRef] [PubMed]
- Pyle, A.; Anugrha, H.; Kurzawa-Akanbi, M.; Yarnall, A.; Burn, D.; Hudson, G. Reduced mitochondrial DNA copy number is a biomarker of Parkinson’s disease. Neurobiol. Aging 2016, 38, 216.e7–216.e10. [Google Scholar] [CrossRef] [PubMed]
- Yu, M. Generation, function and diagnostic value of mitochondrial DNA copy number alterations in human cancers. Life Sci. 2011, 89, 65–71. [Google Scholar] [CrossRef] [PubMed]
- Liu, C.S.; Cheng, W.L.; Lee, C.F.; Ma, Y.S.; Lin, C.Y.; Huang, C.C.; Wei, Y.H. Alteration in the copy number of mitochondrial DNA in leukocytes of patients with mitochondrial encephalomyopathies. Acta Neurol. Scand. 2006, 113, 334–341. [Google Scholar] [CrossRef]
- Galdieri, L.; Zhang, T.; Rogerson, D.; Vancura, A. Reduced Histone Expression or a Defect in Chromatin Assembly Induces Respiration. Mol. Cell. Biol. 2016, 36, 1064–1077. [Google Scholar] [CrossRef]
- Goke, A.; Schrott, S.; Mizrak, A.; Belyy, V.; Osman, C.; Walter, P. Mrx6 regulates mitochondrial DNA copy number in Saccharomyces cerevisiae by engaging the evolutionarily conserved Lon protease Pim1. Mol. Biol. Cell 2020, 31, 527–545. [Google Scholar] [CrossRef]
- Georgieva, M.; Roguev, A.; Balashev, K.; Zlatanova, J.; Miloshev, G. Hho1p, the linker histone of Saccharomyces cerevisiae, is important for the proper chromatin organization in vivo. Biochim. Biophys. Acta 2012, 1819, 366–374. [Google Scholar] [CrossRef]
- Chereji, R.V.; Morozov, A.V. Functional roles of nucleosome stability and dynamics. Brief. Funct. Genom. 2015, 14, 50–60. [Google Scholar] [CrossRef]
- Robinson, P.J.J.; Rhodes, D. Structure of the ‘30nm’ chromatin fibre: A key role for the linker histone. Curr. Opin. Struct. Biol. 2006, 16, 336–343. [Google Scholar] [CrossRef]
- Bao, Y.; Shen, X. SnapShot: Chromatin remodeling: INO80 and SWR1. Cell 2011, 144, 158–158.e2. [Google Scholar] [CrossRef]
- Vasileva, B.; Staneva, D.; Krasteva, N.; Miloshev, G.; Georgieva, M. Changes in Chromatin Organization Eradicate Cellular Stress Resilience to UVA/B Light and Induce Premature Aging. Cells 2021, 10, 1755. [Google Scholar] [CrossRef]
- Miloshev, G.; Staneva, D.; Uzunova, K.; Vasileva, B.; Draganova-Filipova, M.; Zagorchev, P.; Georgieva, M. Linker histones and chromatin remodelling complexes maintain genome stability and control cellular ageing. Mech. Ageing Dev. 2019, 177, 55–65. [Google Scholar] [CrossRef]
- Molon, M.; Stepien, K.; Kielar, P.; Vasileva, B.; Lozanska, B.; Staneva, D.; Ivanov, P.; Kula-Maximenko, M.; Molestak, E.; Tchorzewski, M.; et al. Actin-Related Protein 4 and Linker Histone Sustain Yeast Replicative Ageing. Cells 2022, 11, 2754. [Google Scholar] [CrossRef]
- Georgieva, M.; Staneva, D.; Uzunova, K.; Efremov, T.; Balashev, K.; Harata, M.; Miloshev, G. The linker histone in Saccharomyces cerevisiae interacts with actin-related protein 4 and both regulate chromatin structure and cellular morphology. Int. J. Biochem. Cell B 2015, 59, 182–192. [Google Scholar] [CrossRef]
- Georgieva, M.; Staneva, D.; Uzunova, K.; Miloshev, G. The Deletion of the Gene for the Linker Histone in Arp 4 Mutant Yeast Cells Is Not Deleterious. Biotechnol. Biotec. Eq. 2012, 26, 134–139. [Google Scholar] [CrossRef]
- Hu, J.; Wei, M.; Mirisola, M.G.; Longo, V.D. Assessing chronological aging in Saccharomyces cerevisiae. Methods Mol. Biol. 2013, 965, 463–472. [Google Scholar] [CrossRef]
- Harata, M.; Zhang, Y.; Stillman, D.J.; Matsui, D.; Oma, Y.; Nishimori, K.; Mochizuki, R. Correlation between chromatin association and transcriptional regulation for the Act3p/Arp4 nuclear actin-related protein of Saccharomyces cerevisiae. Nucleic Acids Res. 2002, 30, 1743–1750. [Google Scholar] [CrossRef]
- Ye, J.; Coulouris, G.; Zaretskaya, I.; Cutcutache, I.; Rozen, S.; Madden, T.L. Primer-BLAST: A tool to design target-specific primers for polymerase chain reaction. BMC Bioinform. 2012, 13, 134. [Google Scholar] [CrossRef]
- Zeng, X.; Barros, M.H.; Shulman, T.; Tzagoloff, A. ATP25, a new nuclear gene of Saccharomyces cerevisiae required for expression and assembly of the Atp9p subunit of mitochondrial ATPase. Mol. Biol. Cell 2008, 19, 1366–1377. [Google Scholar] [CrossRef]
- Livak, K.J.; Schmittgen, T.D. Analysis of relative gene expression data using real-time quantitative PCR and the 2(-Delta Delta C(T)) Method. Methods 2001, 25, 402–408. [Google Scholar] [CrossRef]
- Podlesniy, P.; Trullas, R. Absolute measurement of gene transcripts with Selfie-digital PCR. Sci. Rep. 2017, 7, 8328. [Google Scholar] [CrossRef] [PubMed]
- Podlesniy, P.; Trullas, R. Biomarkers in Cerebrospinal Fluid: Analysis of Cell-Free Circulating Mitochondrial DNA by Digital PCR. Methods Mol. Biol. 2018, 1768, 111–126. [Google Scholar] [CrossRef] [PubMed]
- Ludovico, P.; Sansonetty, F.; Corte-Real, M. Assessment of mitochondrial membrane potential in yeast cell populations by flow cytometry. Microbiology 2001, 147, 3335–3343. [Google Scholar] [CrossRef] [PubMed]
- Georgieva, M.; Harata, M.; Miloshev, G. The nuclear actin-related protein Act3p/Arp4 influences yeast cell shape and bulk chromatin organization. J. Cell. Biochem. 2008, 104, 59–67. [Google Scholar] [CrossRef] [PubMed]
- Uzunova, K.; Georgieva, M.; Miloshev, G. Saccharomyces cerevisiae Linker Histone-Hho1p Maintains Chromatin Loop Organization during Ageing. Oxid. Med. Cell. Longev. 2013, 2013, 437146. [Google Scholar] [CrossRef]
- Ephrussi, B.; Hottinguer, H.; Chimenes, A.M. Action de l’acriflavine sur les levures. I. La mutation ‘petite colonie. Ann. Inst. Pasteur. 1949, 76, 351–367. [Google Scholar]
- Hampsey, M. A review of phenotypes in Saccharomyces cerevisiae. Yeast 1997, 13, 1099–1133. [Google Scholar] [CrossRef]
- Dujon, B. Mitochondrial genetics and function. In The Molecular Biology of the Yeast Saccharomyces: Life Cycle and Inheritance; Strathern, J.N., Jones, E.W., Broach, J.R., Eds.; Cold Spring Harbor Laboratory Press: Cold Spring Harbor, NY, USA, 1981; pp. 505–635. [Google Scholar]
- Piskur, J. Inheritance of the yeast mitochondrial genome. Plasmid 1994, 31, 229–241. [Google Scholar] [CrossRef]
- Sherman, F. Respiration-deficient mutants of yeast. I. Genetics. Genetics 1963, 48, 375–385. [Google Scholar] [CrossRef]
- Holt, I.J.; He, J.; Mao, C.C.; Boyd-Kirkup, J.D.; Martinsson, P.; Sembongi, H.; Reyes, A.; Spelbrink, J.N. Mammalian mitochondrial nucleoids: Organizing an independently minded genome. Mitochondrion 2007, 7, 311–321. [Google Scholar] [CrossRef]
- Kukat, C.; Wurm, C.A.; Spahr, H.; Falkenberg, M.; Larsson, N.G.; Jakobs, S. Super-resolution microscopy reveals that mammalian mitochondrial nucleoids have a uniform size and frequently contain a single copy of mtDNA. Proc. Natl. Acad. Sci. USA 2011, 108, 13534–13539. [Google Scholar] [CrossRef]
- Bonekamp, N.A.; Larsson, N.G. SnapShot: Mitochondrial Nucleoid. Cell 2018, 172, 388–388.e381. [Google Scholar] [CrossRef]
- Miyakawa, I. Organization and dynamics of yeast mitochondrial nucleoids. Proc. Jpn. Acad. Ser. B Phys Biol. Sci. 2017, 93, 339–359. [Google Scholar] [CrossRef]
- Dujon, B.; Colleaux, L.; Jacquier, A.; Michel, F.; Monteilhet, C. Mitochondrial introns as mobile genetic elements: The role of intron-encoded proteins. Basic Life Sci. 1986, 40, 5–27. [Google Scholar] [CrossRef]
- Foury, F.; Roganti, T.; Lecrenier, N.; Purnelle, B. The complete sequence of the mitochondrial genome of Saccharomyces cerevisiae. FEBS Lett. 1998, 440, 325–331. [Google Scholar] [CrossRef]
- Tzagoloff, A.; Myers, A.M. Genetics of mitochondrial biogenesis. Annu. Rev. Biochem. 1986, 55, 249–285. [Google Scholar] [CrossRef]
- Dujon, B. Group I introns as mobile genetic elements: Facts and mechanistic speculations—A review. Gene 1989, 82, 91–114. [Google Scholar] [CrossRef]
- Wickens, A.P. Ageing and the free radical theory. Respir. Physiol. 2001, 128, 379–391. [Google Scholar] [CrossRef]
- Vina, J.; Borras, C.; Miquel, J. Theories of ageing. IUBMB Life 2007, 59, 249–254. [Google Scholar] [CrossRef]
- Gruber, J.; Schaffer, S.; Halliwell, B. The mitochondrial free radical theory of ageing—Where do we stand? Front Biosci. 2008, 13, 6554–6579. [Google Scholar] [CrossRef]
- Sharma, A.; Smith, H.J.; Yao, P.; Mair, W.B. Causal roles of mitochondrial dynamics in longevity and healthy aging. EMBO Rep. 2019, 20, e48395. [Google Scholar] [CrossRef] [PubMed]
- Ziada, A.S.; Smith, M.R.; Cote, H.C.F. Updating the Free Radical Theory of Aging. Front. Cell Dev. Biol. 2020, 8, 575645. [Google Scholar] [CrossRef] [PubMed]
- Lauri, A.; Pompilio, G.; Capogrossi, M.C. The mitochondrial genome in aging and senescence. Ageing Res. Rev. 2014, 18, 1–15. [Google Scholar] [CrossRef] [PubMed]
- Giorgi, C.; Marchi, S.; Simoes, I.C.; Ren, Z.; Morciano, G.; Perrone, M.; Patalas-Krawczyk, P.; Borchard, S.; Jędrak, P.; Pierzynowska, K.; et al. Mitochondria and Reactive Oxygen Species in Aging and Age-Related Diseases, 1st ed.; Elsevier Inc.: Amsterdam, The Netherlands; Academic Press: Cambridge, MA, USA, 2018; Volume 340. [Google Scholar]
- Cree, L.M.; Patel, S.K.; Pyle, A.; Lynn, S.; Turnbull, D.M.; Chinnery, P.F.; Walker, M. Age-related decline in mitochondrial DNA copy number in isolated human pancreatic islets. Diabetologia 2008, 51, 1440–1443. [Google Scholar] [CrossRef]
- He, Y.H.; Lu, X.; Wu, H.; Cai, W.W.; Yang, L.Q.; Xu, L.Y.; Sun, H.P.; Kong, Q.P. Mitochondrial DNA content contributes to healthy aging in Chinese: A study from nonagenarians and centenarians. Neurobiol. Aging 2014, 35, 1779.e1–1779.e4. [Google Scholar] [CrossRef]
- Dujon, B.; Slonimski, P.P.; Weill, L. Mitochondrial genetics IX: A model for recombination and segregation of mitochondrial genomes in Saccharomyces cerevisiae. Genetics 1974, 78, 415–437. [Google Scholar] [CrossRef]
- Hori, A.; Yoshida, M.; Shibata, T.; Ling, F. Reactive oxygen species regulate DNA copy number in isolated yeast mitochondria by triggering recombination-mediated replication. Nucleic Acids Res. 2009, 37, 749–761. [Google Scholar] [CrossRef]
- Solieri, L. Mitochondrial inheritance in budding yeasts: Towards an integrated understanding. Trends Microbiol. 2010, 18, 521–530. [Google Scholar] [CrossRef]
- Pfeiffer, T.; Morley, A. An evolutionary perspective on the Crabtree effect. Front Mol. Biosci. 2014, 1, 17. [Google Scholar] [CrossRef]
- De Deken, R.H. The Crabtree effect: A regulatory system in yeast. J. Gen. Microbiol. 1966, 44, 149–156. [Google Scholar] [CrossRef]
- Trumbly, R.J. Glucose repression in the yeast Saccharomyces cerevisiae. Mol. Microbiol. 1992, 6, 15–21. [Google Scholar] [CrossRef]
- Stevens, B.J. Variation in number and volume of mitochondria in yeast according to growth conditions. A study based on serial sectioning and computer graphics reconstruction. Biol. Cell 1977, 28, 37–56. [Google Scholar]
- Visser, W.; van Spronsen, E.A.; Nanninga, N.; Pronk, J.T.; Kuenen, J.G.; van Dijken, J.P. Effects of growth conditions on mitochondrial morphology in Saccharomyces cerevisiae. Antonie Leeuwenhoek 1995, 67, 243–253. [Google Scholar] [CrossRef]
- Aung-Htut, M.T.; Lam, Y.T.; Lim, Y.L.; Rinnerthaler, M.; Gelling, C.L.; Yang, H.; Breitenbach, M.; Dawes, I.W. Maintenance of mitochondrial morphology by autophagy and its role in high glucose effects on chronological lifespan of Saccharomyces cerevisiae. Oxid. Med. Cell. Longev. 2013, 2013, 636287. [Google Scholar] [CrossRef]
- Johnson, L.V.; Walsh, M.L.; Bockus, B.J.; Chen, L.B. Monitoring of relative mitochondrial membrane potential in living cells by fluorescence microscopy. J. Cell Biol. 1981, 88, 526–535. [Google Scholar] [CrossRef]
- Ferlini, C.; Biselli, R.; Nisini, R.; Fattorossi, A. Rhodamine 123: A useful probe for monitoring T cell activation. Cytometry 1995, 21, 284–293. [Google Scholar] [CrossRef]
- Gokerkucuk, E.B.; Tramier, M.; Bertolin, G. Imaging Mitochondrial Functions: From Fluorescent Dyes to Genetically-Encoded Sensors. Genes 2020, 11, 125. [Google Scholar] [CrossRef]
- Piper, P.W.; Jones, G.W.; Bringloe, D.; Harris, N.; MacLean, M.; Mollapour, M. The shortened replicative life span of prohibitin mutants of yeast appears to be due to defective mitochondrial segregation in old mother cells. Aging Cell 2002, 1, 149–157. [Google Scholar] [CrossRef]
- Kaeberlein, M.; Hu, D.; Kerr, E.O.; Tsuchiya, M.; Westman, E.A.; Dang, N.; Fields, S.; Kennedy, B.K. Increased life span due to calorie restriction in respiratory-deficient yeast. PLoS Genet. 2005, 1, e69. [Google Scholar] [CrossRef]
- Krutmann, J.; Schroeder, P. Role of mitochondria in photoaging of human skin: The defective powerhouse model. J. Investig. Dermatol. Symp. Proc. 2009, 14, 44–49. [Google Scholar] [CrossRef]
- Panich, U.; Sittithumcharee, G.; Rathviboon, N.; Jirawatnotai, S. Ultraviolet Radiation-Induced Skin Aging: The Role of DNA Damage and Oxidative Stress in Epidermal Stem Cell Damage Mediated Skin Aging. Stem. Cells Int. 2016, 2016, 7370642. [Google Scholar] [CrossRef] [PubMed]
- Gut, P.; Verdin, E. The nexus of chromatin regulation and intermediary metabolism. Nature 2013, 502, 489–498. [Google Scholar] [CrossRef] [PubMed]
- Picard, M.; McManus, M.J.; Gray, J.D.; Nasca, C.; Moffat, C.; Kopinski, P.K.; Seifert, E.L.; McEwen, B.S.; Wallace, D.C. Mitochondrial functions modulate neuroendocrine, metabolic, inflammatory, and transcriptional responses to acute psychological stress. Proc. Natl. Acad. Sci. USA 2015, 112, E6614–E6623. [Google Scholar] [CrossRef] [PubMed]
- Schroeder, E.A.; Raimundo, N.; Shadel, G.S. Epigenetic silencing mediates mitochondria stress-induced longevity. Cell Metab. 2013, 17, 954–964. [Google Scholar] [CrossRef] [PubMed]
- Son, J.M.; Lee, C. Aging: All roads lead to mitochondria. Semin. Cell Dev. Biol. 2021, 116, 160–168. [Google Scholar] [CrossRef]
- Wiese, M.; Bannister, A.J. Two genomes, one cell: Mitochondrial-nuclear coordination via epigenetic pathways. Mol. Metab. 2020, 38, 100942. [Google Scholar] [CrossRef]
- Zubko, E.I.; Zubko, M.K. Deficiencies in mitochondrial DNA compromise the survival of yeast cells at critically high temperatures. Microbiol. Res. 2014, 169, 185–195. [Google Scholar] [CrossRef]
- Lee, S.; Jeong, S.Y.; Lim, W.C.; Kim, S.; Park, Y.Y.; Sun, X.; Youle, R.J.; Cho, H. Mitochondrial fission and fusion mediators, hFis1 and OPA1, modulate cellular senescence. J. Biol. Chem. 2007, 282, 22977–22983. [Google Scholar] [CrossRef]
- Vasileiou, P.V.S.; Evangelou, K.; Vlasis, K.; Fildisis, G.; Panayiotidis, M.I.; Chronopoulos, E.; Passias, P.G.; Kouloukoussa, M.; Gorgoulis, V.G.; Havaki, S. Mitochondrial Homeostasis and Cellular Senescence. Cells 2019, 8, 686. [Google Scholar] [CrossRef]
- Sahabi, S.; Jafari-Gharabaghlou, D.; Zarghami, N. A new insight into cell biological and biochemical changes through aging. Acta Histochem. 2022, 124, 151841. [Google Scholar] [CrossRef]
- Lee, H.C.; Yin, P.H.; Chi, C.W.; Wei, Y.H. Increase in mitochondrial mass in human fibroblasts under oxidative stress and during replicative cell senescence. J. Biomed. Sci. 2002, 9, 517–526. [Google Scholar] [CrossRef]
- Hermann, G.J.; Shaw, J.M. Mitochondrial dynamics in yeast. Annu. Rev. Cell Dev. Biol. 1998, 14, 265–303. [Google Scholar] [CrossRef]
- Delsite, R.; Kachhap, S.; Anbazhagan, R.; Gabrielson, E.; Singh, K.K. Nuclear genes involved in mitochondria-to-nucleus communication in breast cancer cells. Mol. Cancer 2002, 1, 6. [Google Scholar] [CrossRef]
- Lu, H.; Shu, Q.; Lou, H.; Chen, Q. Mitochondria-Mediated Programmed Cell Death in Saccharomyces cerevisiae Induced by Betulinic Acid Is Accelerated by the Deletion of PEP4 Gene. Microorganisms 2019, 7, 538. [Google Scholar] [CrossRef]
- Lisowsky, T.; Michaelis, G. A nuclear gene essential for mitochondrial replication suppresses a defect of mitochondrial transcription in Saccharomyces cerevisiae. Mol. Gen. Genet. MGG 1988, 214, 218–223. [Google Scholar] [CrossRef]
- Taylor, S.D.; Zhang, H.; Eaton, J.S.; Rodeheffer, M.S.; Lebedeva, M.A.; O’Rourke, T.W.; Siede, W.; Shadel, G.S. The conserved Mec1/Rad53 nuclear checkpoint pathway regulates mitochondrial DNA copy number in Saccharomyces cerevisiae. Mol. Biol. Cell 2005, 16, 3010–3018. [Google Scholar] [CrossRef]
- Kulawiec, M.; Ayyasamy, V.; Singh, K.K. p53 regulates mtDNA copy number and mitocheckpoint pathway. J. Carcinog. 2009, 8, 8. [Google Scholar] [CrossRef]
- Devin, A.B.; Prosvirova, T.; Peshekhonov, V.T.; Chepurnaya, O.V.; Smirnova, M.E.; Koltovaya, N.A.; Troitskaya, E.N.; Arman, I.P. The start gene CDC28 and the genetic stability of yeast. Yeast 1990, 6, 231–243. [Google Scholar] [CrossRef]
- Chen, S.; Liu, D.; Finley, R.L., Jr.; Greenberg, M.L. Loss of mitochondrial DNA in the yeast cardiolipin synthase crd1 mutant leads to up-regulation of the protein kinase Swe1p that regulates the G2/M transition. J. Biol. Chem. 2010, 285, 10397–10407. [Google Scholar] [CrossRef]
- Genta, H.D.; Monaco, M.E.; Aon, M.A. Decreased mitochondrial biogenesis in temperature-sensitive cell division cycle mutants of Saccharomyces cerevisiae. Curr. Microbiol. 1995, 31, 327–331. [Google Scholar] [CrossRef]
- Zimmermann, C.; Chymkowitch, P.; Eldholm, V.; Putnam, C.D.; Lindvall, J.M.; Omerzu, M.; Bjørås, M.; Kolodner, R.D.; Enserink, J.M. A chemical-genetic screen to unravel the genetic network of CDC28/CDK1 links ubiquitin and Rad6–Bre1 to cell cycle progression. Proc. Natl. Acad. Sci. USA 2011, 108, 18748–18753. [Google Scholar] [CrossRef] [PubMed]
- Yamamoto, H.; Kakuta, S.; Watanabe, T.M.; Kitamura, A.; Sekito, T.; Kondo-Kakuta, C.; Ichikawa, R.; Kinjo, M.; Ohsumi, Y. Atg9 vesicles are an important membrane source during early steps of autophagosome formation. J. Cell Biol. 2012, 198, 219–233. [Google Scholar] [CrossRef] [PubMed]
- Xu, P.; Damschroder, D.; Zhang, M.; Ryall, K.A.; Adler, P.N.; Saucerman, J.J.; Wessells, R.J.; Yan, Z. Atg2, Atg9 and Atg18 in mitochondrial integrity, cardiac function and healthspan in Drosophila. J. Mol. Cell. Cardiol. 2019, 127, 116–124. [Google Scholar] [CrossRef] [PubMed]
- Obara, K.; Sekito, T.; Niimi, K.; Ohsumi, Y. The Atg18-Atg2 complex is recruited to autophagic membranes via phosphatidylinositol 3-phosphate and exerts an essential function. J. Biol. Chem. 2008, 283, 23972–23980. [Google Scholar] [CrossRef]
- Hibshman, J.D.; Leuthner, T.C.; Shoben, C.; Mello, D.F.; Sherwood, D.R.; Meyer, J.N.; Baugh, L.R. Nonselective autophagy reduces mitochondrial content during starvation in Caenorhabditis elegans. Am. J. Physiol. Cell Physiol. 2018, 315, C781–C792. [Google Scholar] [CrossRef]
- Herrera, E.L.; Azzam, S.Z.; Berger, M.C.; Diaz-Martinez, L.A. Genomic heterogeneity meets cellular energetics: Crosstalk between the mitochondria and the cell cycle. J. Cancer Metastasis Treat 2018, 4, 42. [Google Scholar] [CrossRef]
- Murphy, E.; Ardehali, H.; Balaban, R.S.; DiLisa, F.; Dorn, G.W., 2nd; Kitsis, R.N.; Otsu, K.; Ping, P.; Rizzuto, R.; Sack, M.N.; et al. Mitochondrial Function, Biology, and Role in Disease: A Scientific Statement From the American Heart Association. Circ. Res. 2016, 118, 1960–1991. [Google Scholar] [CrossRef]
- Basel, D. Mitochondrial DNA Depletion Syndromes. Clin. Perinatol. 2020, 47, 123–141. [Google Scholar] [CrossRef]
- Rusecka, J.; Kaliszewska, M.; Bartnik, E.; Tonska, K. Nuclear genes involved in mitochondrial diseases caused by instability of mitochondrial DNA. J. Appl. Genet. 2018, 59, 43–57. [Google Scholar] [CrossRef]
- Lambert, A.J.; Brand, M.D. Reactive oxygen species production by mitochondria. Methods Mol. Biol. 2009, 554, 165–181. [Google Scholar] [CrossRef]
- López-Otín, C.; Blasco, M.A.; Partridge, L.; Serrano, M.; Kroemer, G. Hallmarks of aging: An expanding universe. Cell 2023, 186, 243–278. [Google Scholar] [CrossRef]
- Lopez-Otin, C.; Galluzzi, L.; Freije, J.M.P.; Madeo, F.; Kroemer, G. Metabolic Control of Longevity. Cell 2016, 166, 802–821. [Google Scholar] [CrossRef]
- Medkour, Y.; Dakik, P.; McAuley, M.; Mohammad, K.; Mitrofanova, D.; Titorenko, V.I. Mechanisms Underlying the Essential Role of Mitochondrial Membrane Lipids in Yeast Chronological Aging. Oxid. Med. Cell. Longev. 2017, 2017, 2916985. [Google Scholar] [CrossRef]
- Dakik, P.; Titorenko, V.I. Communications between Mitochondria, the Nucleus, Vacuoles, Peroxisomes, the Endoplasmic Reticulum, the Plasma Membrane, Lipid Droplets, and the Cytosol during Yeast Chronological Aging. Front Genet. 2016, 7, 177. [Google Scholar] [CrossRef]
- Hughes, A.L.; Gottschling, D.E. An early age increase in vacuolar pH limits mitochondrial function and lifespan in yeast. Nature 2012, 492, 261–265. [Google Scholar] [CrossRef]

| Strain | Genotype | Ref. | |
|---|---|---|---|
| Abbreviation | Name | ||
| WT | DY2864 | MATa his4-912δ-ADE2 his4-912δ lys2-128δ can1 trp1 ura3 ACT3 | [39] |
| hho1Δ | DY2864 hho1Δ | MATa his4-912δ-ADE2 his4-912δ lys2-128δ can1 trp1 ura3 ACT3 YPL127C::KLURA3 | [29,36] |
| arp4 | DY4285 | MATa his4-912δ-ADE2 lys2-128δ can1 leu2 trp1 ura3 act3-ts26 | [39] |
| arp4 hho1Δ | DY4285 hho1Δ | MATa his4-912δ-ADE2 lys2-128δ can1 leu2 trp1 ura3 act3-ts26 YPL127C::KLURA3 | [29,36] |
| Primers | Gene | Amplicon № | * Coordinates | ** bp | |
|---|---|---|---|---|---|
| Mitochondrial Gene | mtDNA | ||||
| 1F | GGAGGGCTGTACGAGTTCAA | COX1 exon | I | 16,862–16,935 | 74 |
| 1R | CGTTATCCCCAGGGTTTCCC | ||||
| 2F | ATGATTTTCTGTGCGCCGTT | AI2/COX1 | II | 16,461–16,935 | 475 |
| 1R | CGTTATCCCCAGGGTTTCCC | COX1 exon | |||
| 1F | GGAGGGCTGTACGAGTTCAA | COX1 exon | III | 16,862–17,696 | 835 |
| 2R | ACTGACAACACTACCTTGAGGA | AI2/COX1 | |||
| 2F | ATGATTTTCTGTGCGCCGTT | AI2/COX1 | IV | 16,461–17,696 | 1236 |
| 2R | ACTGACAACACTACCTTGAGGA | ||||
| 3F | CCTCGCGGGGTATGGTAAAT | COX1 intron | V | 20,197–20,281 | 85 |
| 3R | GCATGGGGGTGGGGAAATTA | ||||
| 4F | TACTTTCTTCCCCTCCGAATCC | COX1 intron | VI | 20,009–20,281 | 273 |
| 3R | GCATGGGGGTGGGGAAATTA | ||||
| 3F | CCTCGCGGGGTATGGTAAAT | COX1 intron | VII | 20,197–20,955 | 759 |
| 4R | AGATTGGGTCACCACCTCC | COX1 exon | |||
| 4F | TACTTTCTTCCCCTCCGAATCC | COX1 intron | VIII | 20,009–20,955 | 947 |
| 4R | AGATTGGGTCACCACCTCC | COX1 exon | |||
| 5F | TGGGTGCTATTTTCTCTTTATTTGC | COX1_3′-ex | IX | 26,244–26,673 | 430 |
| 5R | GAGTGTACAGCTGGTGGAGA | ||||
| 6F | CTCTCGGTGGGGGTTCACAC | 21S rRNA | X | 60,489–60,561 | 73 |
| 6R | GACCCGAAAGGGAACCGGAA | ||||
| 6F | CTCTCGGTGGGGGTTCACAC | 21S rRNA | XI | 60,489–61,921 | 1433 |
| 7R | ATCGAGGTGGCAAACATAGC | 21S/SCEI | |||
| 7F | GCCTATAATTGAGGTCCCGC | 21S/SCEI | XII | 59,854–60,561 | 708 |
| 6R | GACCCGAAAGGGAACCGGAA | 21S rRNA | |||
| 7F | GCCTATAATTGAGGTCCCGC | 21S/SCEI | XIII | 59,854–61,921 | 2068 |
| 7R | ATCGAGGTGGCAAACATAGC | ||||
| 8F | TGAAGCTGTACAACCTACCGA | COX3 | XIV | 79,599–79,698 | 100 |
| 8R | ACCTGCGATTAAGGCATGATGA | ||||
| 8F | TGAAGCTGTACAACCTACCGA | COX3 | XV | 79,599–80,017 | 419 |
| 9R | CTCCTCATCAGTAGAAGACTACG | ||||
| 9F | AGAAGTAGACATCAACAACATCCA | COX3 | XVI | 79,228–79,698 | 471 |
| 8R | ACCTGCGATTAAGGCATGATGA | ||||
| 9F | AGAAGTAGACATCAACAACATCCA | COX3 | XVII | 79,228–80,017 | 790 |
| 9R | CTCCTCATCAGTAGAAGACTACG | ||||
| Nuclear mt gene | Gene name | ||||
| ATP25_For | CCACCACACGATGAACAAAGA | ATP25 | YMR098C | 1041 | |
| ATP25_Rev | TGACTAGAATGCTGCGTTTTCA | ||||
| Nuclear gene | Gene name | ||||
| ATG18_For | TTCCCGTTGAAACCAATTCCCA | ATG18 | YFR021W | 98 | |
| ATG18_Rev | GCCAGTTTCGAAGAGTTCCGGAT | ||||
| CDC28_For | AGGAAACCAATCTTCAGTGGCGA | CDC28 | YBR160W | 91 | |
| CDC28_Rev | CTGGCCATATAGCTTCATTCGGC |
| ATG18 | CDC28 | |||||
|---|---|---|---|---|---|---|
| 4 h | 24 h | 72 h | 4 h | 24 h | 72 h | |
| WT | 21.4 ± 1.6 | 3.5 ± 0.0 | 1.5 ± 0.5 | 67.6 ± 0.0 | 8.5 ± 1.9 | 1.6 ± 0.2 |
| hho1Δ | 3.7 ± 1.0 | 1.6 ± 0.3 | 0.3 ± 0.03 | 10.1 ± 1.4 | 1.6 ± 0.0 | 0.8 ± 0.01 |
| arp4 | 13.0 ± 2.4 | 7.4 ± 3.2 | 0.7 ± 0.0 | 40.0 ± 2.8 | 3.1 ± 0.07 | 0.7 ± 0.0 |
| arp4 hho1Δ | 0.7 ± 0.1 | 0.5 ± 0.04 | 1.2 ± 0.3 | 1.5 ± 0.4 | 1.3 ± 0.1 | 0.8 ± 0.4 |
Disclaimer/Publisher’s Note: The statements, opinions and data contained in all publications are solely those of the individual author(s) and contributor(s) and not of MDPI and/or the editor(s). MDPI and/or the editor(s) disclaim responsibility for any injury to people or property resulting from any ideas, methods, instructions or products referred to in the content. |
© 2023 by the authors. Licensee MDPI, Basel, Switzerland. This article is an open access article distributed under the terms and conditions of the Creative Commons Attribution (CC BY) license (https://creativecommons.org/licenses/by/4.0/).
Share and Cite
Staneva, D.; Vasileva, B.; Podlesniy, P.; Miloshev, G.; Georgieva, M. Yeast Chromatin Mutants Reveal Altered mtDNA Copy Number and Impaired Mitochondrial Membrane Potential. J. Fungi 2023, 9, 329. https://doi.org/10.3390/jof9030329
Staneva D, Vasileva B, Podlesniy P, Miloshev G, Georgieva M. Yeast Chromatin Mutants Reveal Altered mtDNA Copy Number and Impaired Mitochondrial Membrane Potential. Journal of Fungi. 2023; 9(3):329. https://doi.org/10.3390/jof9030329
Chicago/Turabian StyleStaneva, Dessislava, Bela Vasileva, Petar Podlesniy, George Miloshev, and Milena Georgieva. 2023. "Yeast Chromatin Mutants Reveal Altered mtDNA Copy Number and Impaired Mitochondrial Membrane Potential" Journal of Fungi 9, no. 3: 329. https://doi.org/10.3390/jof9030329
APA StyleStaneva, D., Vasileva, B., Podlesniy, P., Miloshev, G., & Georgieva, M. (2023). Yeast Chromatin Mutants Reveal Altered mtDNA Copy Number and Impaired Mitochondrial Membrane Potential. Journal of Fungi, 9(3), 329. https://doi.org/10.3390/jof9030329

